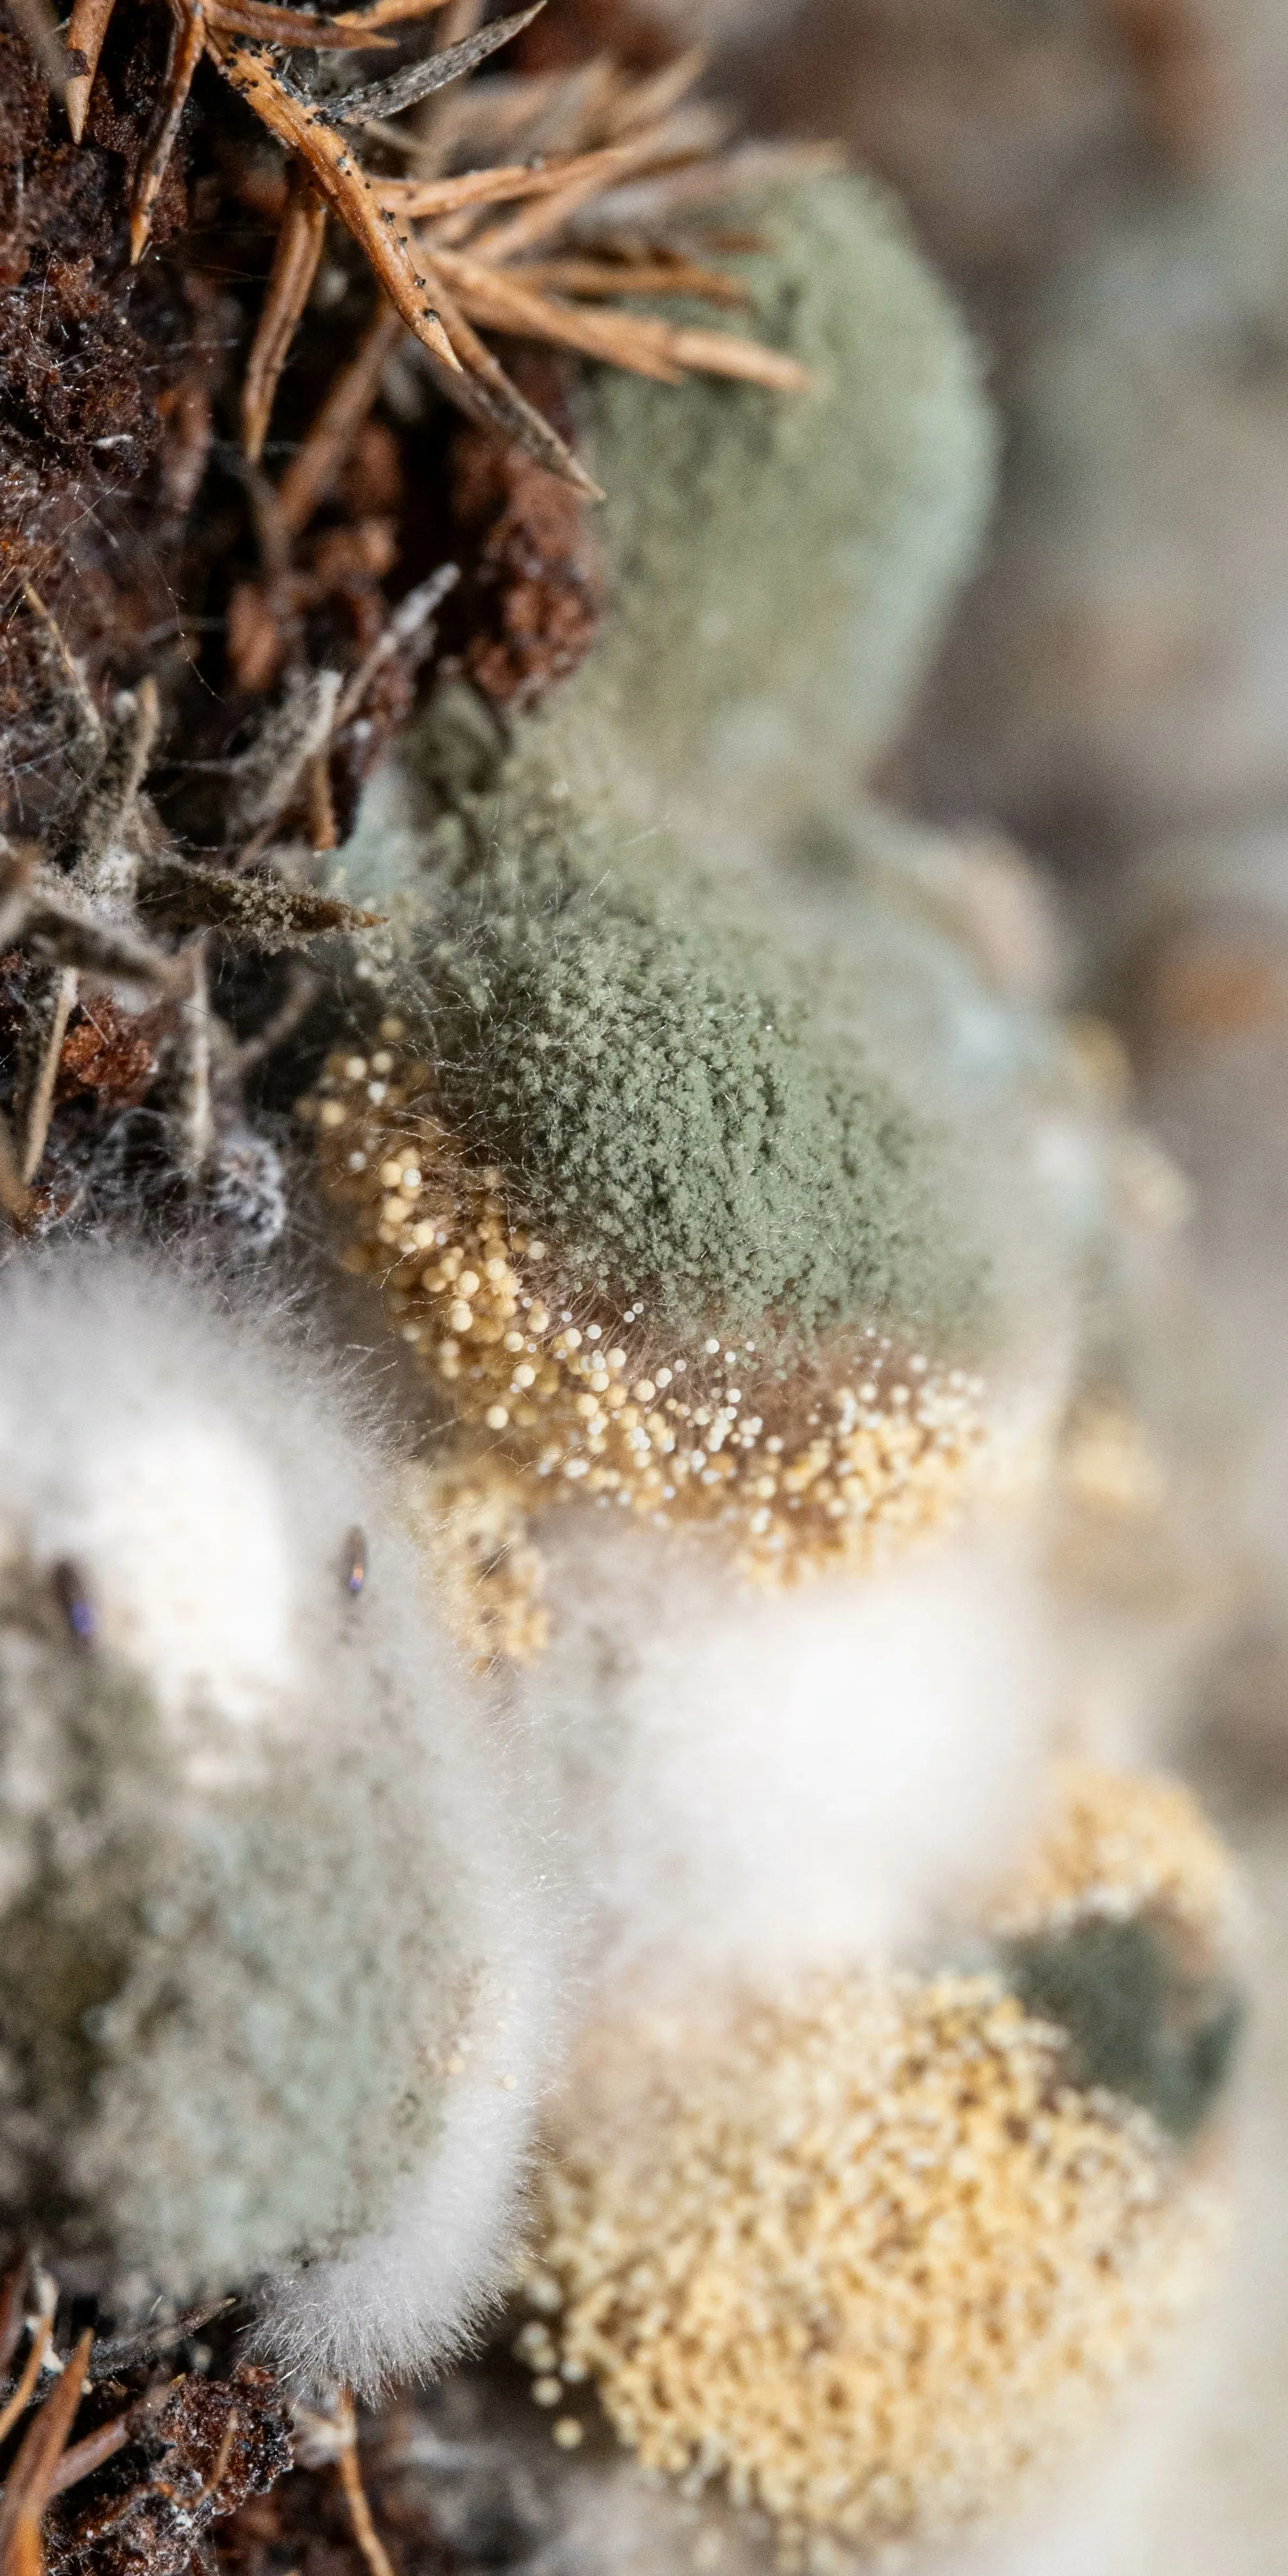

时光荏苒,2024年悄然走向尾声。这一年里,我用镜头记录下776张美好瞬间,按照13个主题精心分类整理,每一帧都诉说着独特的故事与情感。从萌宠的治愈时光到传统文化的厚重魅力,从都市街头的烟火人间到乡野田园的诗意远方,这些影像交织成了我的2024年生活画卷。

传送门
年度回顾
这一年的光影记录,见证了生活的丰富多彩:
- 最温暖系列:家中毛茸茸的小伙伴们,它们的每一个萌态都是生活中的治愈良药
- 最生机系列:从阳台盆栽到路边野花,植物们用顽强的生命力装点着四季轮回
- 最壮丽系列:旅途中的山川湖海,大自然的鬼斧神工让人心旷神怡
- 最真实系列:城市街头的日常百态,平凡生活中蕴含着最朴素的美好
- 最珍贵系列:与家人朋友的温馨时光,这些人间风情是记忆中最珍贵的片段
- 最喜庆系列:节日庆典的红火热闹,传统文化在现代生活中焕发新的活力
- 最诗意系列:乡野田园的宁静致远,远离喧嚣的田埂小径写满了诗和远方
- 最诱人系列:各式美食的色香味俱全,每一道菜都承载着生活的烟火气息
- 最有趣系列:动漫游戏的二次元世界,创意与想象力在现实中精彩绽放
- 最静谧系列:窗外风景的四季变迁,透过玻璃看世界别有一番情趣
- 最细腻系列:微观世界的纹理光影,平凡事物中隐藏着令人惊叹的抽象之美
- 最厚重系列:传统建筑与文化遗韵,历史的沉淀在现代依然散发着独特魅力
每一张照片都是时间的切片,每一次快门都是对美好的定格。2024年即将成为历史,但这776个瞬间会永远珍藏在记忆深处,成为人生路上最美的风景线。愿新的一年,继续用心感受生活,用镜头记录美好,让光影成为岁月最温柔的见证。
]]>